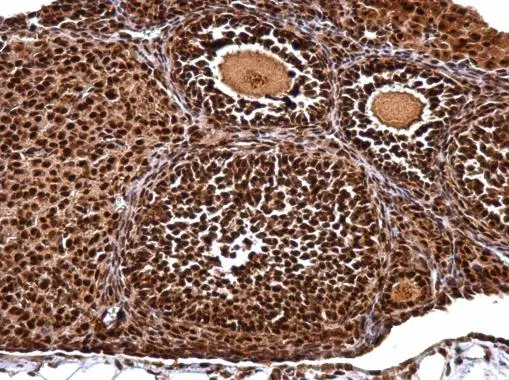
NUDT21 antibody detects NUDT21 protein at nucleus on mouse ovary by immunohistochemical analysis. Sample: Paraffin-embedded mouse ovary. NUDT21 antibody (GTX115535) dilution: 1:500. 
 Antigen Retrieval: Trilogy? (EDTA based, pH 8.0) buffer, 15min

NUDT21 antibody detects NUDT21 protein at nucleus on mouse ovary by immunohistochemical analysis. Sample: Paraffin-embedded mouse ovary. NUDT21 antibody (GTX115535) dilution: 1:500.
Antigen Retrieval: Trilogy? (EDTA based, pH 8.0) buffer, 15min
NUDT21 antibody
GTX115535
ApplicationsImmunoPrecipitation, Western Blot, ImmunoHistoChemistry, ImmunoHistoChemistry Paraffin
Product group Antibodies
ReactivityHuman, Mouse, Parasite, Rat
TargetNUDT21
Overview
- SupplierGeneTex
- Product NameNUDT21 antibody
- Delivery Days Customer9
- Application Supplier NoteWB: 1:500-1:3000. IHC-P: 1:100-1:1000. IP: 1:100-1:500. *Optimal dilutions/concentrations should be determined by the researcher.Not tested in other applications.
- ApplicationsImmunoPrecipitation, Western Blot, ImmunoHistoChemistry, ImmunoHistoChemistry Paraffin
- CertificationResearch Use Only
- ClonalityPolyclonal
- Concentration0.99 mg/ml
- ConjugateUnconjugated
- Gene ID11051
- Target nameNUDT21
- Target descriptionnudix hydrolase 21
- Target synonymsCFIM25, CPSF5, cleavage and polyadenylation specificity factor subunit 5, CPSF 25 kDa subunit, cleavage and polyadenylation specific factor 5, 25 kD subunit, cleavage and polyadenylation specific factor 5, 25 kDa, cleavage and polyadenylation specificity factor 25 kDa subunit, cleavage factor Im complex 25 kDa subunit, nucleoside diphosphate-linked moiety X motif 21, nudix (nucleoside diphosphate linked moiety X)-type motif 21, nudix motif 21, pre-mRNA cleavage factor Im (25kD), pre-mRNA cleavage factor Im 25 kDa subunit, pre-mRNA cleavage factor Im 68 kDa subunit, pre-mRNA cleavage factor Im, 25kD subunit
- HostRabbit
- IsotypeIgG
- Protein IDO43809
- Protein NameCleavage and polyadenylation specificity factor subunit 5
- Scientific DescriptionThe protein encoded by this gene is one subunit of a cleavage factor required for 3 RNA cleavage and polyadenylation processing. The interaction of the protein with the RNA is one of the earliest steps in the assembly of the 3 end processing complex and facilitates the recruitment of other processing factors. This gene encodes the 25kD subunit of the protein complex, which is composed of four polypeptides. [provided by RefSeq]
- ReactivityHuman, Mouse, Parasite, Rat
- Storage Instruction-20°C or -80°C,2°C to 8°C
- UNSPSC41116161